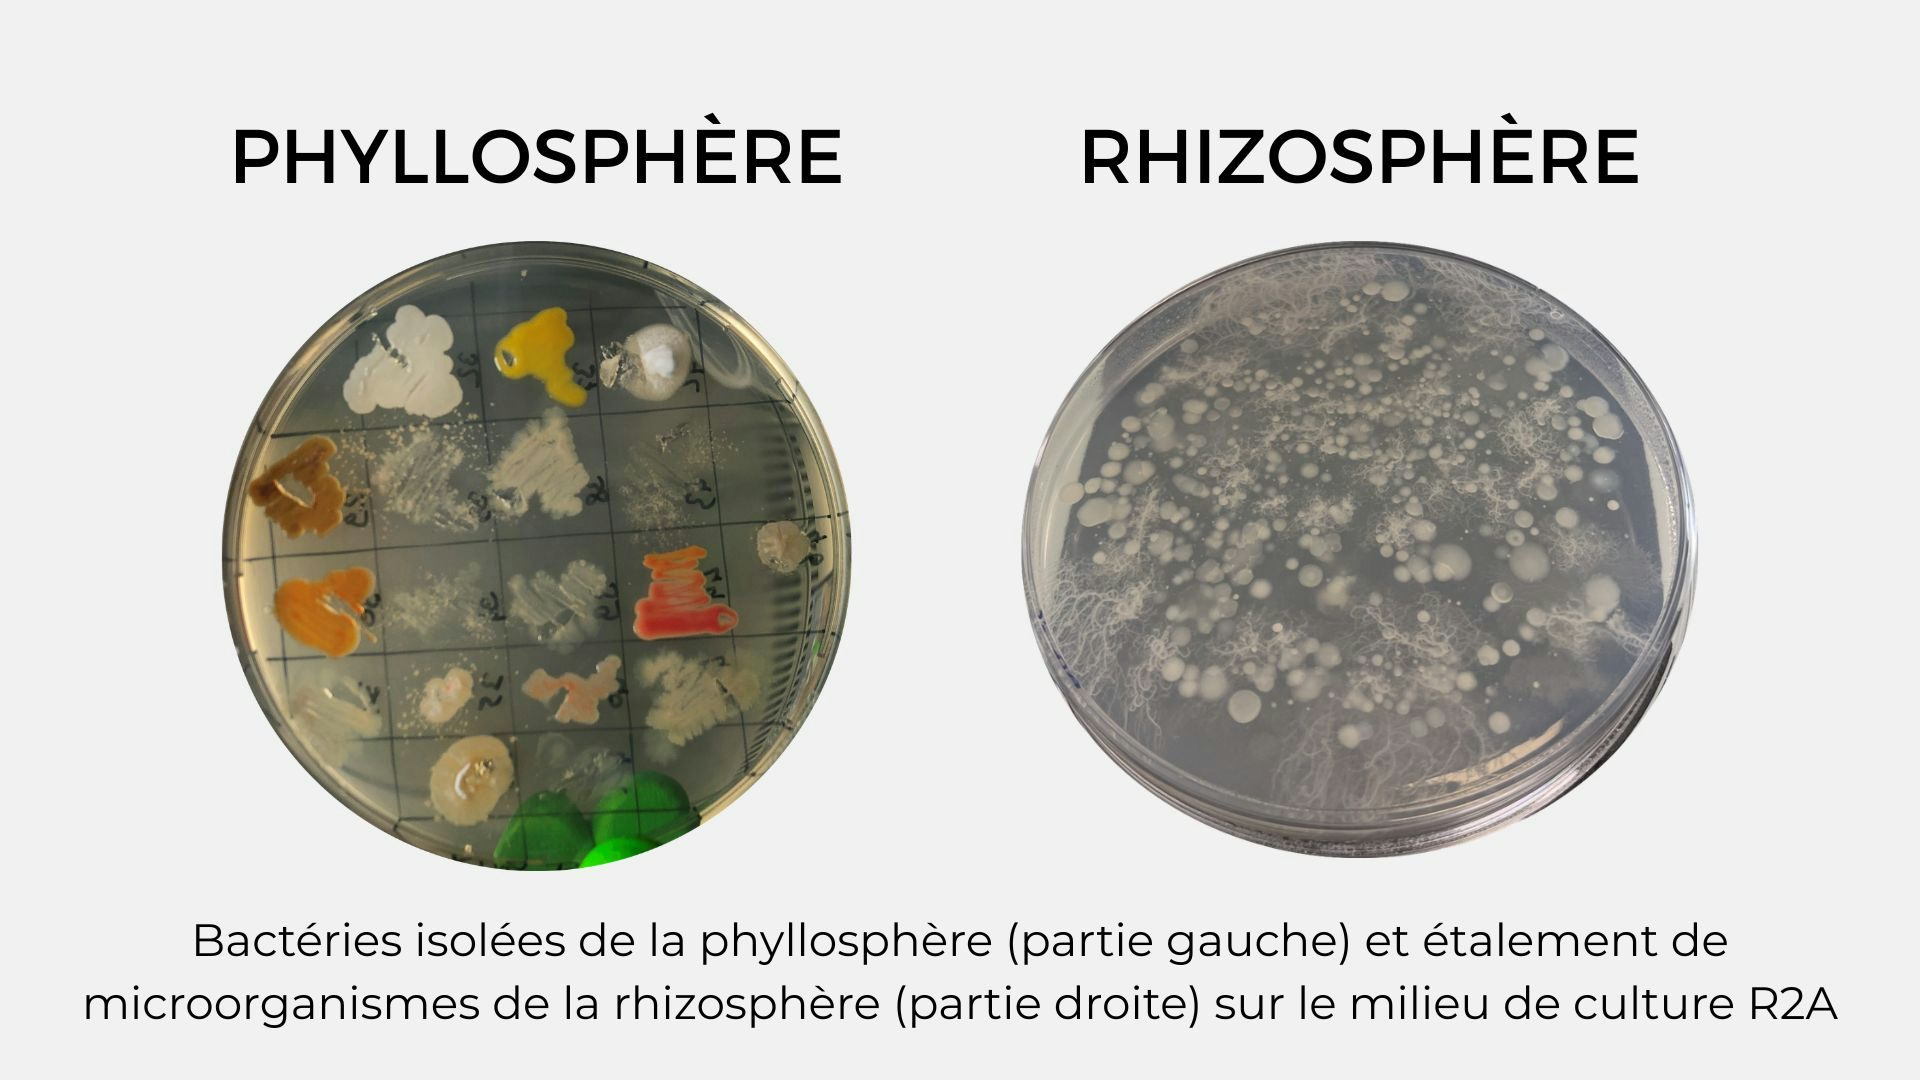
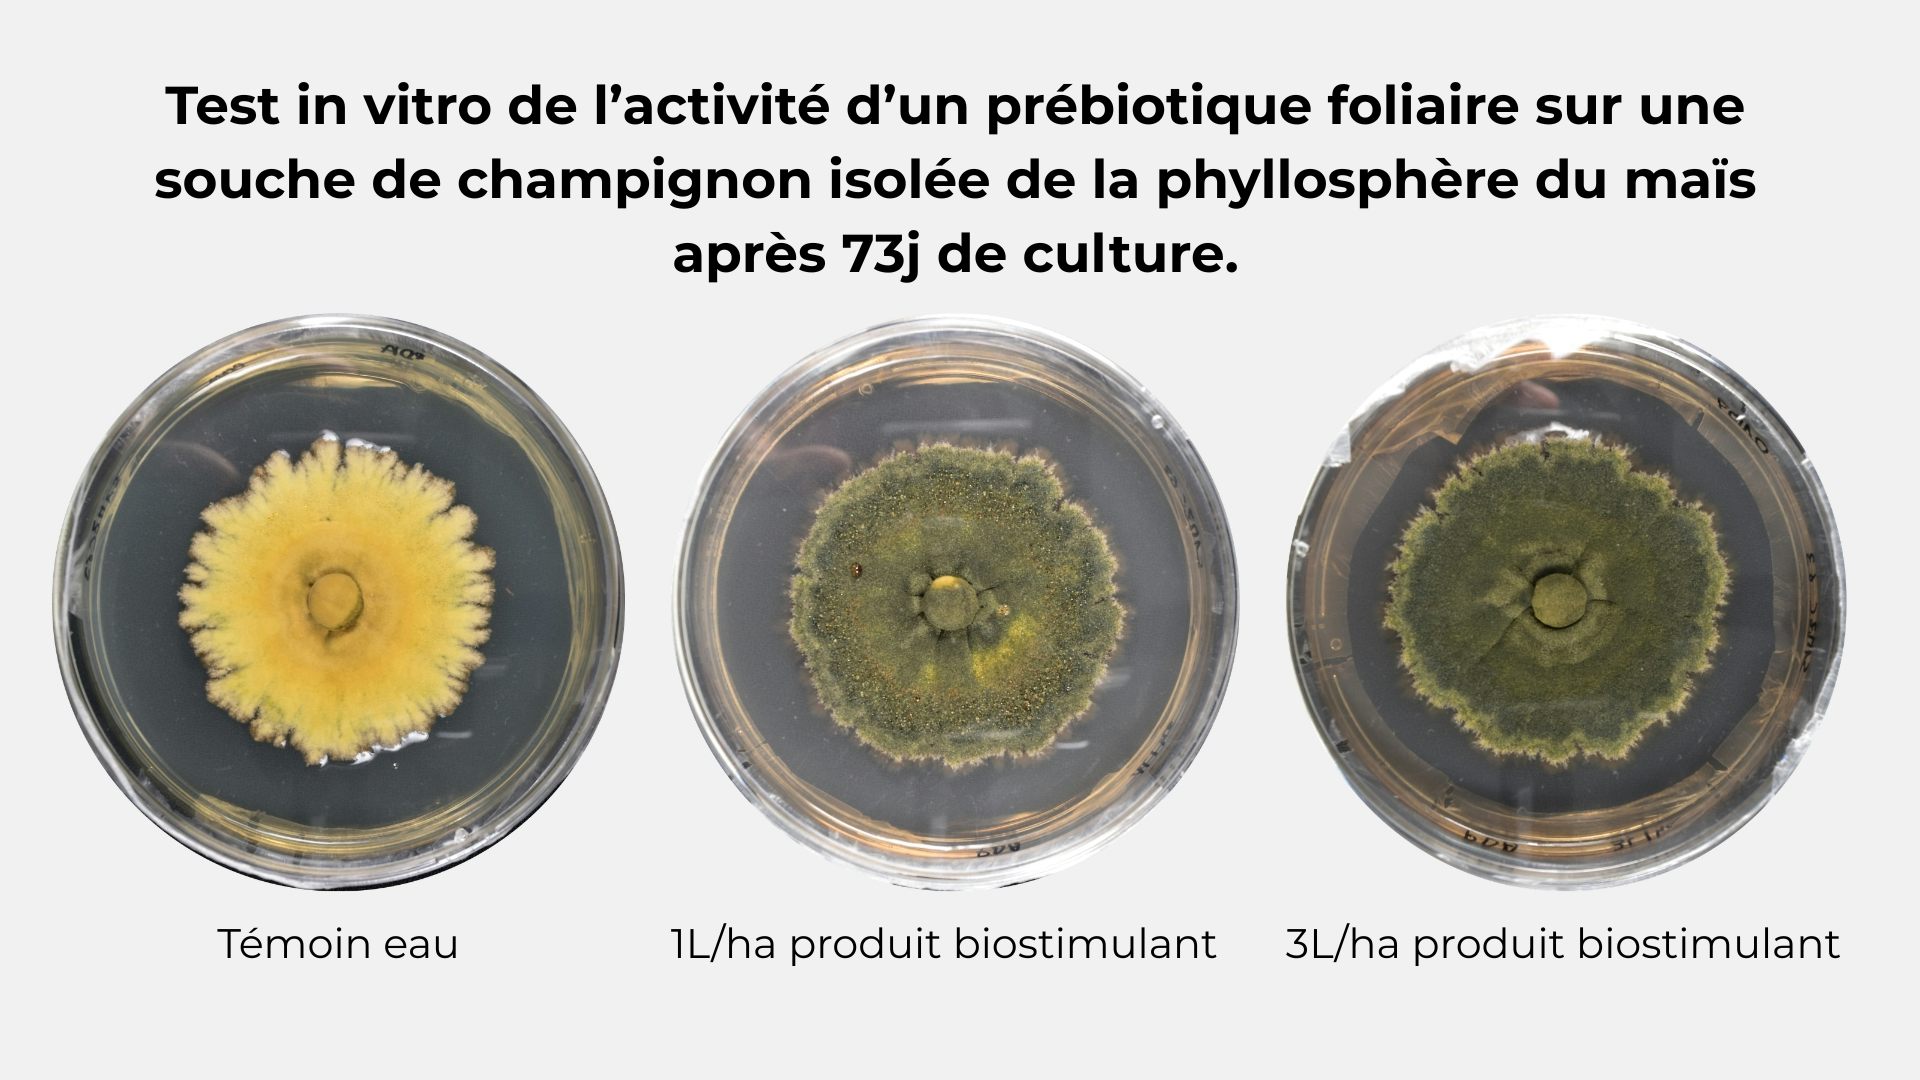

Source: The Conversation – France (in French) – By Mathilde Bouteiller, Chargée de recherche en microbiologie & biologie moléculaire de l’unité AGHYLE, UniLaSalle

Les humains ne sont pas les seuls à être dotés de microbiotes. Les plantes aussi. Les milliers de microorganismes qui vivent sur leurs feuilles sont encore peu connus, mais pleins de potentiels pour accroître leur croissance ou améliorer leur rendement, ou encore leur résistance au stress.
À l’heure où l’utilisation des pesticides et des engrais de synthèse pose de plus en plus question, des alternatives efficaces doivent être trouvées. Parmi les solutions qui sont à l’étude, l’utilisation de produits d’origine naturelle, aussi appelés biosolutions, montre des résultats prometteurs.
Les biostimulants font partie de ces alternatives. Ils peuvent être de diverses origines et contiennent par exemple des extraits d’algues, des microorganismes, comme des champignons ou des bactéries, des extraits végétaux, des acides aminés… On les applique de multiples manières, en les pulvérisant sur les feuilles, en enrobant les graines ou directement dans le sol.
Ces produits fonctionnent en stimulant les processus biologiques naturels des plantes pour améliorer leur nutrition, leur croissance, leur rendement ou leur résistance au stress. Là où un engrais va apporter directement un élément nutritif (comme l’azote, le phosphore, le potassium) propice à la croissance des plantes et où un pesticide sera utilisé pour éradiquer les agresseurs des plantes, les biostimulants vont, eux, permettre à la plante d’augmenter ses propres capacités.
Quels sont les avantages à utiliser des biostimulants foliaires ?
Il existe ainsi plusieurs avantages à utiliser des traitements foliaires plutôt que des traitements au sol.
Premièrement, ces traitements ont une activité plus rapide puisque la solution va pouvoir agir directement sur le métabolisme de la plante, sans trop dépendre de l’environnement très complexe que représente le sol. De plus, les doses utilisées en traitement foliaire sont bien moins importantes que lors d’une application au sol, ce qui rend ces traitements moins onéreux.
Par ailleurs, il est fréquent d’appliquer ce type de traitement en association avec d’autres traitements foliaires (herbicide, fongicide), dont l’effet négatif semble contrebalancé par l’effet du biostimulant.
Quelle est l’influence des biostimulants sur les microbiotes de la plante ?
Ce qui rend également les biostimulants particulièrement intéressants réside dans leur possibilité d’interagir avec le microbiote des plantes. Car les humains ne sont pas les seuls à vivre aux contacts d’une myriade de bactéries, de champignons, et autres microorganismes, qui exercent des fonctions importantes.
Les organismes présents dans les microbiotes de la plante comprennent :
-
des bactéries (microorganismes unicellulaires sans noyau) ;
-
des archées (microorganismes unicellulaires sans noyau formant un règne à part entière différent des bactéries) ;
-
des champignons pluricellulaires produisant du mycélium ;
-
des champignons unicellulaires (comme les levures) ;
-
des algues (végétaux unicellulaires) et des protistes (cellules unicellulaires non classifiables dans le règne animal, végétal ou fongique) ;
-
des virus et des bactériophages (virus qui attaque exclusivement les bactéries).
Chez les végétaux, ces microorganismes sont notamment présents au niveau des sols, des racines et des parties aériennes (tiges, feuilles, fruits et fleurs).
Les biosolutions ou les produits de lutte chimique vont être directement en contact avec ces microorganismes qui constituent le microbiote de la plante.
Plusieurs études ont déjà montré l’impact des biostimulants sur le microbiote au niveau des racines et du sol. Ces microorganismes du sol et des racines sont regroupés sous le nom de rhizosphère. Des biosolutions appliqués au sol sont, par exemple, capables de modifier les communautés microbiennes du sol, notamment en augmentant l’abondance en champignons mycorhiziens (champignons connus pour améliorer l’acquisition de nutriments par les plantes, qui favoriseraient la croissance et le rendement des cultures).
Malheureusement, à l’heure actuelle, peu d’études sur les microorganismes présents au niveau des parties aériennes des plantes, aussi appelés phyllosphère, sont recensées. Pourtant, nous savons que ces microorganismes exercent une activité globalement positive sur les plantes hôtes et qu’ils sont directement influencés par les produits appliqués sur les feuilles.

Fourni par l’auteur
Au sein de la phyllosphère, les microorganismes sont capables d’interagir entre eux ainsi qu’avec leurs plantes hôtes avec lesquelles ils entretiennent une relation symbiotique, c’est-à-dire une association biologique, durable et réciproquement profitable, entre deux organismes vivants.
De ce fait, ce microbiote joue un rôle important dans le développement et la nutrition des plantes. Par ailleurs, comme cela est observé pour le microbiote cutané chez l’humain, la présence de microorganismes sur la surface des parties aériennes permet à la plante de se protéger et de prévenir de l’attaque d’organismes pathogènes. Une étude montre par exemple que certains membres de la communauté microbienne des feuilles fournissent une protection significative contre un agent pathogène chez l’arabette des dames, une plante à fleur très commune en Europe.
Mais pour mieux comprendre toutes les potentialités des alliances bénéfiques qui se jouent au niveau des feuilles des plantes, point de mystère, il faut mieux les connaître, et les étudier.
Étudier la phyllosphère
Pour étudier les microbiotes, on analyse généralement l’ADN des microorganismes.
La métagénomique est une méthode d’analyse fondée sur la technique de séquençage des ADN (déterminer la séquence des bases de tous les gènes du génome) d’un environnement donné. Avec cette méthode, l’étude des microorganismes prédominants dans un milieu spécifique est possible grâce à l’identification de ces microorganismes, en comparant leurs séquences avec des séquences de microorganismes déjà identifiés dans des bases de données appelées BLAST. Avec la métagénomique, on peut également connaître les fonctions que jouent ces microorganismes. Ces techniques, très à la mode, sont utilisées puisqu’elles présentent l’avantage de ne pas être basées sur la mise en culture de microorganismes parfois très difficile voire impossible.
Cependant, les études basées sur l’ADN ne permettent pas de distinguer l’ADN de microorganismes morts ou vivants et de savoir si ces microorganismes sont actifs. Au sein du laboratoire AGHYLE, le microbiote de la phyllosphère est donc étudié en parallèle par la mise en culture de certains microorganismes sur boîte de Pétri, bien que ces derniers ne représentent que quelques pourcents du microbiote total.
Les bactéries obtenues et isolées de la phyllosphère présentent généralement une grande diversité de couleur, de texture et d’aspect. La coloration permet aux microorganismes de mieux résister aux UV, ce qui est un avantage sélectif, car ils doivent être capables de résister aux rayons du soleil à la différence de ceux de la rhizosphère. Certaines bactéries forment des colonies très mucoïdes (grasses) ce qui les rendent également plus résistantes à la sécheresse.
Fourni par l’auteur
Plusieurs études indiquent que des microorganismes provenant de la phyllosphère présentent des activités bénéfiques pour les plantes. Par exemple, sur la phyllosphère, les bactéries Methylobacterium sont reconnues pour stimuler la croissance des plantes et les protéger des bioagresseurs.
D’autres bactéries isolées de la phyllosphère de la tomate, comme Bacillus velezensis 83, sont également dotées de capacité de stimulation de la croissance des plantes et de protection des cultures.
Au sein du laboratoire, nous avons identifié des bactéries et les champignons isolés de la phyllosphère de la tomate Solanum lycopersicum (variété MicroTom) et du maïs (Zea mays L. variété DATABAZ). En comparant les séquences d’ADN obtenues avec une banque de données internationales (BLAST), nous avons pu identifier le genre et parfois aussi l’espèce de ces microorganismes et vérifier qu’ils s’agissaient bien de microorganismes connus et provenant de la phyllosphère.
Parmi les microorganismes identifiés, plusieurs sont connus dans la littérature et pourraient appartenir aux bactéries ou aux champignons promoteurs de la croissance des plantes et/ou présenter des effets de biocontrôle. D’autres ne sont que partiellement identifiés, et nous ne pouvons donc pas encore savoir s’ils sont bénéfiques ou pathogènes.

Fourni par l’auteur
Bien qu’il soit possible d’utiliser directement des bactéries ou des champignons isolés de l’environnement naturel pour booster la croissance et la protection des plantes, la colonisation et la capacité des microorganismes à fonctionner en champ reste difficile à prévoir.
De plus, le stockage de microorganismes est bien plus compliqué que ne l’est un biostimulant. Dans ce sens, le développement de solutions agissant directement sur les microorganismes déjà présents sur les plantes, reste une alternative prometteuse pour l’agriculture. Ainsi, pour tester des biostimulants de manière peu onéreuse et rapide, nous réalisons au laboratoire des tests in vitro (en boîte de Pétri) sur les microorganismes de la phyllosphère. Le développement des microorganismes est suivi au cours du temps et la morphologie du développement bactérien et mycélien est observée.
Fourni par l’auteur
Dans la figure ci-dessus, on observe l’effet d’un biostimulant foliaire sur un champignon, isolé de la phyllosphère du maïs. Bien que la taille du mycélium ne semble pas impactée, la présence du biostimulant semble affecter le champignon. Mais plusieurs questions restent en suspens : est-ce que ce biostimulant induit la même chose chez tous les microorganismes de la phyllosphère ? Ne va-t-il pas stimuler la croissance d’organismes pathogènes ?
Ces résultats préliminaires offrent des perspectives intéressantes, mais doivent encore être approfondis.
![]()
Les premières expérimentations portant sur la phyllosphère ont été initiées dans le cadre des travaux menés au sein de la Chaire Biomes, en partenariat avec l’entreprise Gaïago.
Guillemette Garry ne travaille pas, ne conseille pas, ne possède pas de parts, ne reçoit pas de fonds d’une organisation qui pourrait tirer profit de cet article, et n’a déclaré aucune autre affiliation que son organisme de recherche.
– ref. Les microbes qui vivent sur les feuilles : un monde invisible essentiel à la santé des plantes – https://theconversation.com/les-microbes-qui-vivent-sur-les-feuilles-un-monde-invisible-essentiel-a-la-sante-des-plantes-276204
